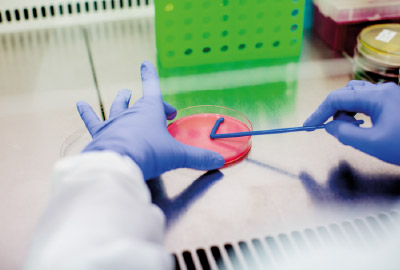
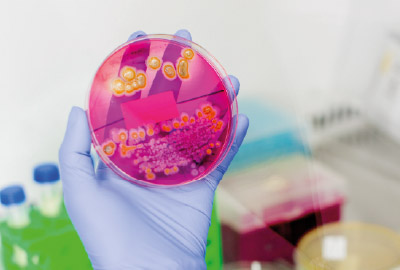

Investigación en enfermedades infecciosas y tropicales
Investigación
Las líneas de investigación del Instituto Colombiano de Medicina Tropical se enfocan en el estudio de enfermedades infecciosas, principalmente enfermedades tropicales. Nuestras innovadoras líneas investigativas comprenden desde estudios básicos de los patógenos, los vectores y los huéspedes, hasta investigación aplicada, incluyendo el desarrollo de pruebas de diagnóstico.

Entomología

Micobacterias
Microbiología
Microbiología industrial y ambiental

Parasitología

Salud Pública

Virología

Zoonosis
Investigadores
Juan David Ospina Villa
Investigador junior, profesor instructor ICMT-CES
Bacteriólogo, MSc., PhD., investigador senior, profesor asistente ICMT-CES
Paola Alexandra García Huertas
Investigadora junior, profesora instructora ICMT-CES
Bióloga, MSc., PhD., investigadora junior, profesora asistente ICMT-CES
Héctor Alejandro Serrano Coll
Investigador junior, profesor instructor ICMT-CES
Médico, MSc., PhD., investigador asociado, profesor asistente ICMT-CES
Margarita Arboleda Naranjo
Coordinadora ICMT Apartadó, investigadora senior, profesora titular ICMT-CES
Médica, MSc., PhD. Honoris Causa, investigadora senior, profesora titular ICMT-CES
Giovanny Torres Lindarte
Investigador asociado, profesor asistente ICMT-CES
Bacteriólogo MSc., DrSci., investigador senior, profesor asociado ICMT-CES
Catalina Alfonso Parra
Investigadora junior, profesora asistente ICMT-CES
Microbióloga, PhD., investigadora asociada, profesora asociada ICMT-CES
Ángela María Tobón Orozco
Investigadora junior, profesora asistente ICMT-CES
Médica y cirujana, especialista en Medicina Interna, investigadora junior, profesora asistente ICMT-CES
Miryan Margot Sánchez Jiménez
Investigadora senior, profesora titular
Bacterióloga, MSc., DrSci., investigadora senior, profesora titular ICMT-CES
Luis Ernesto López Rojas
Director ICMT, investigador junior, profesor titular ICMT-CES
Biólogo, MSc., MBA., PhD., investigador junior, profesor titular ICMT-CES

Colección entomológica
La Colección Entomológica del Instituto Colombiano de Medicina Tropical (CEICMT) fue fundada en 1998. Contiene 3535 registros de insectos de importancia en salud pública recolectados en varios departamentos de Colombia y otros países de América por diversos investigadores del Instituto.
La misión de la CEICMT es promover y contribuir al conocimiento científico de los insectos transmisores (vectores) de las enfermedades que afectan a la población colombiana.












